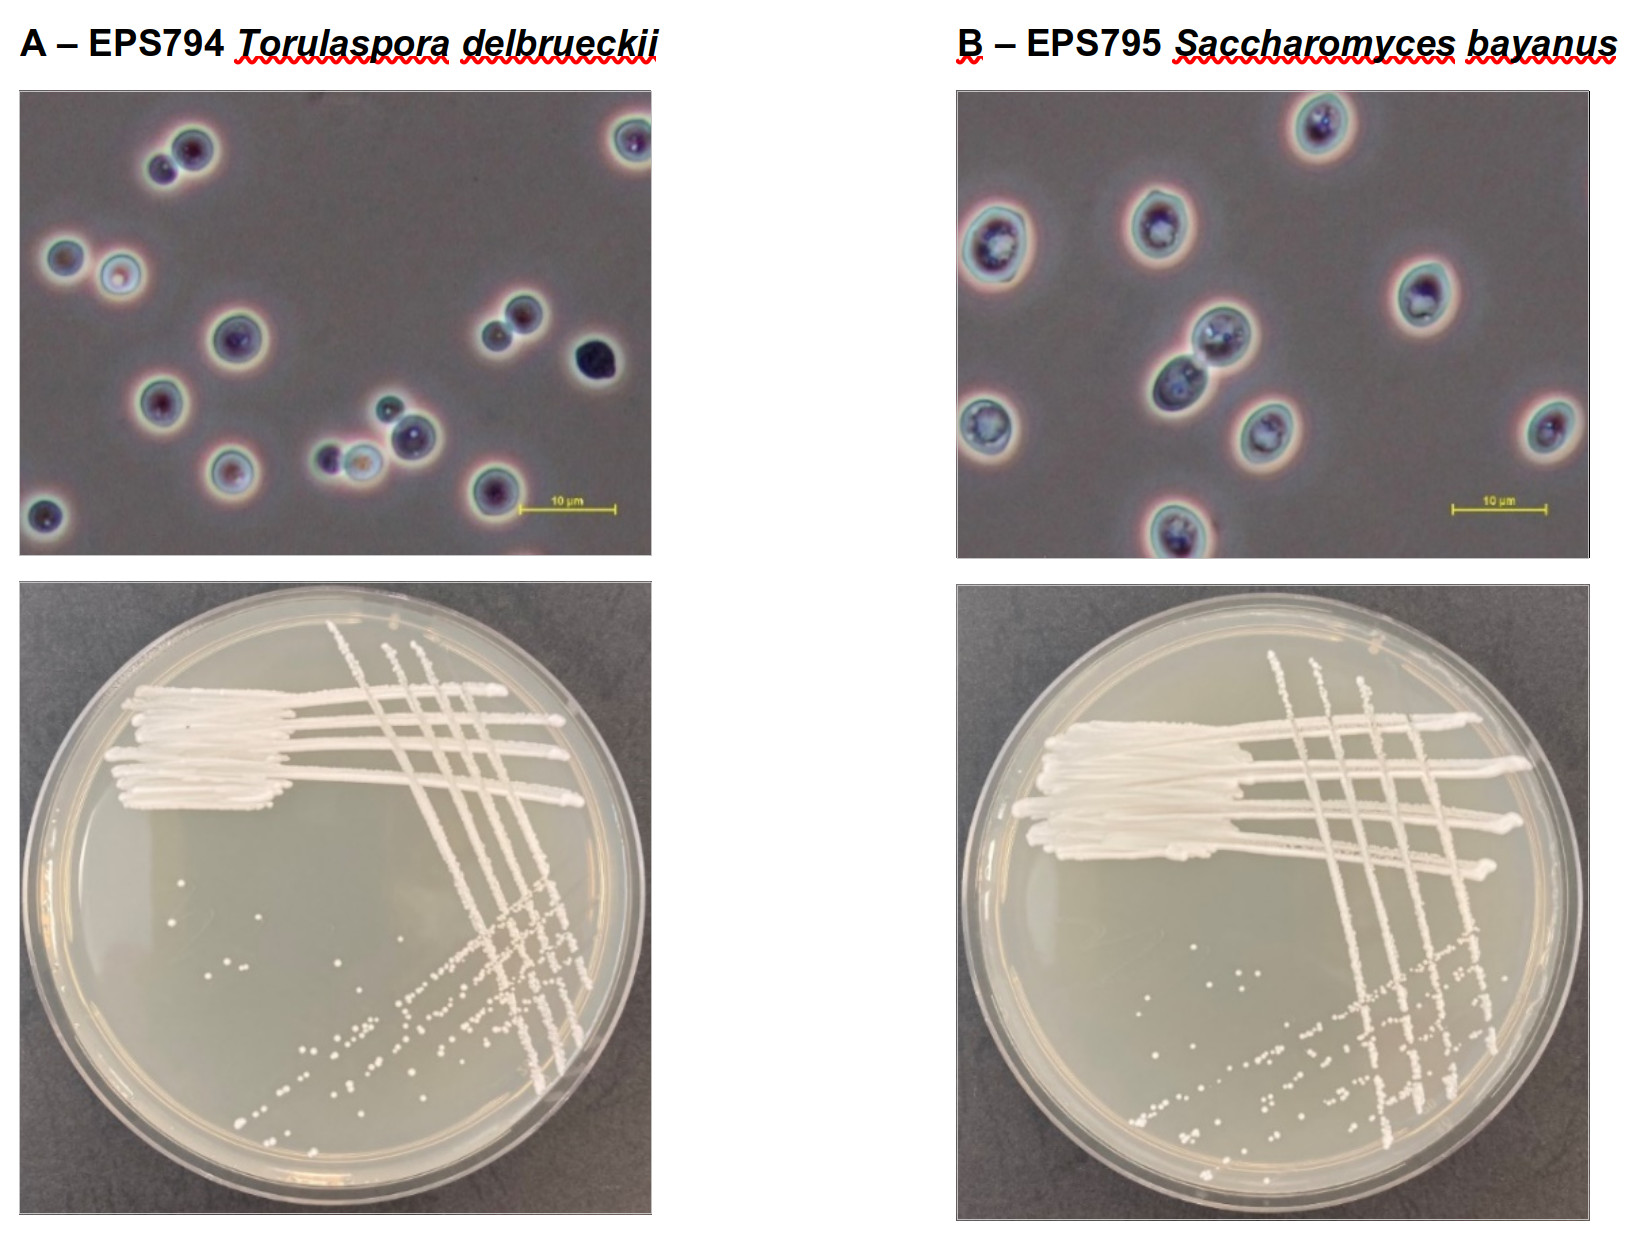

15. 3. 2025 Chmelovárek
Na soutěži tzv. domovarníků jsme prezentovali mimo jiné i kvasinky pro výrobu nealkoholických a nízkoalkoholických piv, které byly vyselektovány v rámci projektu MikroPivo. Cílem bylo oslovit tento segment trhu a zájemce edukovat o využívání kvasinek selektovaných ve společnosti EPS biotechnology. Součástí prezentaci byl i stánek, kde jsme nabízeli naše služby a prodávali lyofilizované kvasinky.
2. 13. 2024 BrewerShop 2024
Pro sládky a provozovatele minipivovarů jsme připravili první ročník obchodně - edukačního semináře BrewerShop. Jedním z témat, které bylo prezentováno, byla výroba nealkoholických a nízkoalkoholických piv prostřednictvím kvasinkových izolátů EPS794 a EPS795. Posluchači byli seznámeni s technologickými kroky a rovněž s riziky, které výroba tohoto segmentu piv obnáší.
23. 7. 2024 EPS Webinář 2024
Online webináře jsou důležitou a populární vzdělávací platformou. Proto jsme připravili a vysílali webinář, který měl za cíl jednak propagovat kvasinky určené na výrobu nealkoholických a nízkoalkoholických piv EPS794 a EPS795 a současně edukovat sládky ohledně technologie výroby nízkoalkoholických a nealkoholických piv.
23. 11. 2023 Envishop 2023
Semináře ENVIshop jsou mnoho let místem setkávání specialistů a odborné veřejnosti. Také zde jsme prezentovali dosažené výsledky grantových projektů. Konkrétně se jednalo o prezentaci "Reálné dopady výzkumných projektů". Auditorium bylo informováno o důvodech, které vedly k tvorbě projektu, o stručném průběhu jeho realizace a jak probíhá uplatňování výsledků v praxi.